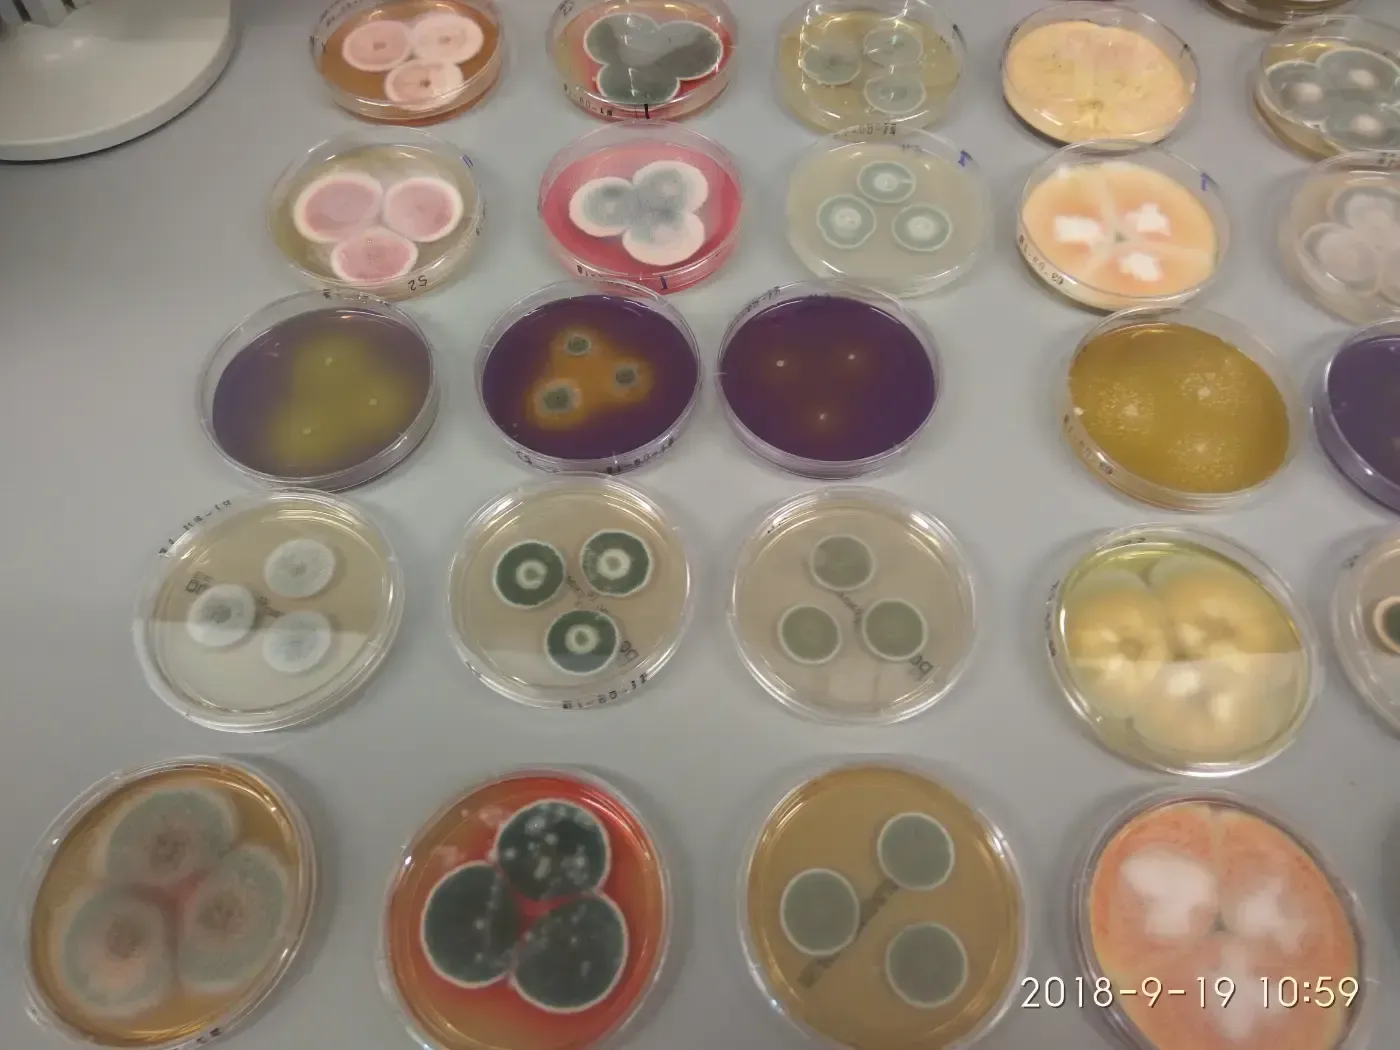
Verschiedene kleine runde Behälter mit bunten, gemusterten Perlen oder Bastelmaterialien, die in Reihen auf einem Tisch angeordnet sind.

Ihre Spezialisten für Hygieneanalytik und Laboruntersuchungen
Zuverlässige Analysen, fundierte Bewertungen und persönliche Beratung in den Bereichen Wasser, Lebensmittel, Krankenhaushygiene und Schimmelpilze – aus Eberswalde.
Hygienisch-technische Analysen für sichere Ergebnisse
Kompetenz, auf die Sie sich verlassen können
Die LWU Lebensmittel-, Wasser- und Umwelthygiene GmbH ist Ihr zuverlässiger Partner für hygienisch-technische Laboruntersuchungen, Analysen und Hygieneüberprüfungen. Unser Leistungsspektrum umfasst die Bereiche Wasseranalytik, Lebensmittelanalytik, Krankenhaushygiene sowie die Schimmelpilzanalytik. Mit modernen Laboreinrichtungen, akkreditierten Verfahren und langjähriger Erfahrung unterstützen wir sowohl Unternehmen als auch Privatkunden bei der Sicherstellung von Qualität, Hygiene und gesetzlichen Anforderungen. Dabei legen wir besonderen Wert auf präzise Ergebnisse, individuelle Beratung und eine vertrauensvolle Zusammenarbeit.

Wasseranalytik – zuverlässig und normgerecht geprüft
Wir analysieren verschiedenste Wasserarten nach aktuellen gesetzlichen Vorgaben und normierten Verfahren – inklusive Probenahme, Auswertung und fachlicher Beratung.
Trink- & Brunnenwasser
Analyse nach Trinkwasserverordnung zur Sicherstellung der Wasserqualität.
Legionellenprüfung
Systemische Untersuchungen von Warmwasserversorgungsanlagen gemäß gesetzlichen Anforderungen.
Abwasseranalytik
Regelmäßige Überprüfung entsprechend wasserrechtlicher Vorgaben und Genehmigungen.
Kühlwasseranalysen
Mikrobiologische Untersuchungen nach 42. BImSchV zur sicheren Anlagenüberwachung.
Schwimm- & Badebeckenwasser
Kontrollen gemäß DIN 19643 für hygienisch einwandfreies Badewasser.
Ihre Vorteile mit LWU
Zertifizierte
Qualität
Unsere Analysen erfolgen nach akkreditierten Verfahren gemäß DIN EN ISO/IEC 17025 und erfüllen alle relevanten gesetzlichen Anforderungen.
Individuelle Fachberatung
Wir begleiten Sie persönlich – von der ersten Anfrage über die Probenahme bis zur verständlichen Auswertung der Ergebnisse.
Umfassendes Leistungsspektrum
Von Wasser- und Lebensmittelanalytik bis hin zu Krankenhaushygiene und Schimmelpilzanalysen erhalten Sie bei uns alle Leistungen aus einer Hand.
Weitere Leistungen rund um Hygiene und Analytik
Neben der Wasseranalytik bieten wir Ihnen ein breites Spektrum an weiteren Untersuchungen und Hygienekontrollen für unterschiedlichste Anforderungen.
Lebensmittelanalytik
Mikrobiologische Untersuchungen, Hygieneprüfungen und Prozesskontrollen für sichere Lebensmittelqualität.
Krankenhaushygiene
Funktionsprüfungen und Hygienekontrollen in medizinischen Einrichtungen für maximale Sicherheit im Betrieb.
Schimmelpilzanalytik
Nachweis und Bewertung von Schimmelpilzen in Innenräumen zur Einschätzung gesundheitlicher Risiken.

Sie benötigen eine Analyse oder haben Fragen zu unseren Leistungen?
Unser Team berät Sie gerne persönlich und unterstützt Sie bei allen Fragen rund um Analytik, Hygiene und gesetzliche Anforderungen.